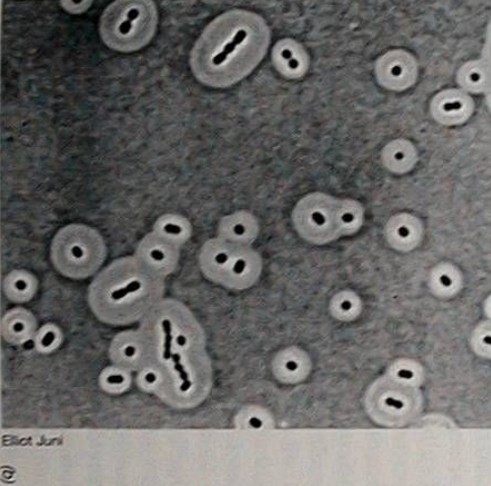
荚膜染色
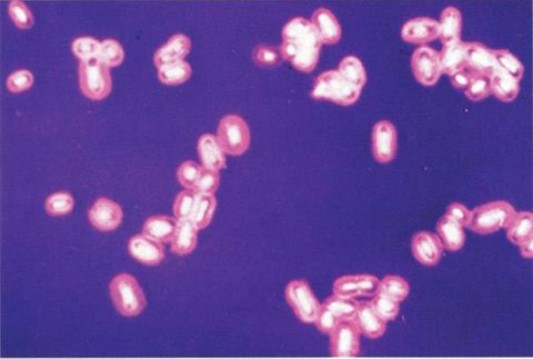
荚膜染色

荚膜显微镜下图片

荚膜
图片尺寸750x750
荚膜厚度一般>0.2μm,在普通光学显微镜下可见,若厚度 0.
图片尺寸587x359告诉你一种观测荚膜的新方法
图片尺寸1280x1328
产气荚膜梭菌显微镜图
图片尺寸450x299荚膜染色
图片尺寸491x486
印度墨汁染色的肺炎克氏杆菌的荚膜.jpg
图片尺寸500x287
写美篇产气荚膜梭菌(clostredum perfringens)亦称威尔什菌.
图片尺寸1123x1080
荚膜
图片尺寸300x225
那么利用什么方法能够使我们在普通光学显微镜下清楚地观察到细菌荚膜
图片尺寸700x527
imicro 中国科学技术大学 显微摄影比赛
图片尺寸907x635
脑室引流液隐球菌荚膜抗原阳性墨汁染色却看不到隐球菌
图片尺寸631x623
荚膜染色
图片尺寸220x136荚膜染色
图片尺寸533x359隐球菌感染▍病例解析上述显微镜照片,为检验科提供的,并诊断为新型
图片尺寸1280x960
褐球固氮菌涂片(示荚膜)-涂片-求精教学(查看)
图片尺寸699x700
荚膜
图片尺寸220x153粪便中遇见鬼脸
图片尺寸900x506
2um以上,普通显微镜可见,与四周有明显界限,称为荚膜.
图片尺寸371x323
农大印象丨一菌一物一世界显微镜下别样美
图片尺寸259x264
肺炎链球菌荚膜
图片尺寸811x547
猜你喜欢:显微镜下的霉菌芽孢杆菌显微镜图片破伤风梭菌显微镜图片荚膜染色绘图荚膜染色手绘图显微镜下鞭毛图片细菌荚膜手绘图细菌荚膜染色手绘图鞭毛图片手绘图荚膜染色螺旋菌显微镜下图片血小板显微镜下图片显微镜下的细菌动图芽孢图片鞭毛图片细菌荚膜图片弧菌显微镜下图片荚膜芽孢显微镜细菌显微镜下的图片鞭毛显微镜下图片人血涂片显微镜图片显微镜下的细菌图片显微镜图片结构图细菌图片显微镜显微镜图片酵母菌显微镜下图片荚膜图片显微镜图片植物细胞显微镜图片卡通groza突击步枪西派浣花二期刘雯新发型洪水高清发财老鼠头像图片大全gd头像权志龙动漫图片西游记妖怪分类整理久石让mother简谱歌谱王天生白坡蒸鱼简笔画 可爱纯白壁纸 长方形山姆·克拉弗林 剧照